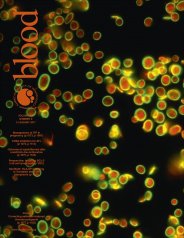

Seznam časopisů
Název časopisu
- AJHG – The American Journal of Human Genetics
- Blood
- Cell
- Cell – Host & Microbe
- Cell – Immunity
- Cell – Stem Cell
- Cytotherapy
- European Journal of Human Genetics
- Human Reproduction
- JEM – The Journal of Experimental Medicine
- JID – Journal of Investigative Dermatology
- Nature
- Nature Genetics
- Nature Immunology
- Nature Reviews Cancer
- Nature Reviews Genetics
- Nature Reviews Immunology
- Nature Reviews Microbiology
- Nature Reviews Rheumatology
- NEJM – The New England Journal of Medicine
- Pediatrics
- PNAS – Proceedings of the National Academy of Sciences of the United States of America
- Reproduction – The Journal of the Society for Reproduction and Fertility
- Science
- The Journal of Allergy and Clinical Immunology
- The Journal of Immunology
- The Lancet
- Transplantation and Cellular Therapy
Blood
Minulá vydání